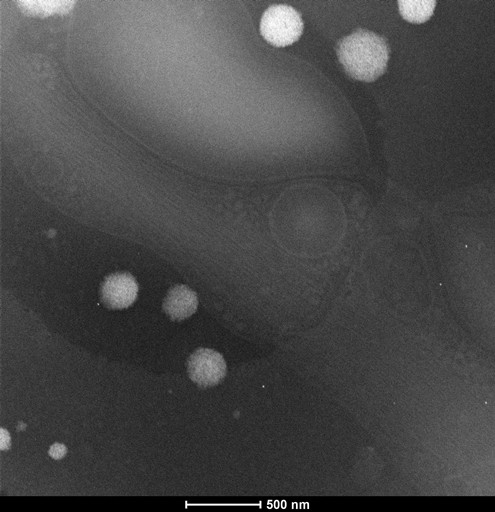

fig1:EFTEM_15k_1.6e_2K_2
Courtesy of Xiaojun Huang, CBI, IBP, CAS, China
Image Details:
Instrument used: FEI Titan Krios FEG TEM
Accelerating voltage: 300kV
Imaging mode: EFTEM without filter
Magnification: 15000x
Dose: 1.6e-/?
fig2.STEM-1_80K_sp6_ft40_cl542_2k_1-Acquire HAADF Scanning Display1-Acquire HAADF-1
Courtesy of Xiaojun Huang, CBI, IBP, CAS, China
Image Details:
Instrument used: FEI Titan Krios FEG TEM
Accelerating voltage: 300kV
Imaging mode: HAADF STEM
Magnification: 80000x
Gun len:8; Extraction Voltage:4500V; Spot:6; C2 condenser aperture:50μm;
pixel size:1.6nm; camera length: 542mm; dwell time:8 μs